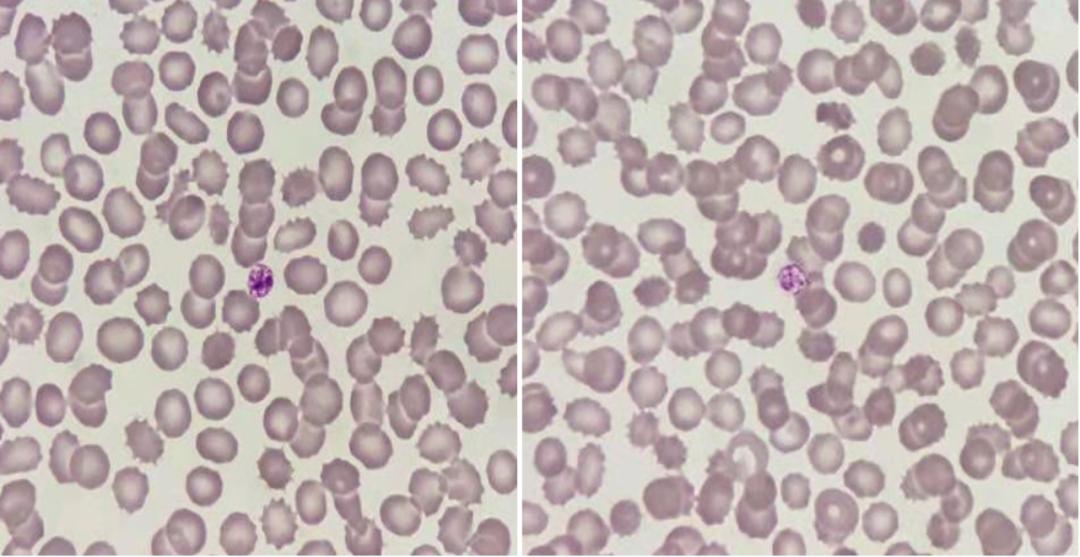
是谁揭开了血小板减少的面纱?

作者:邱文辉
单位:滦州市人民医院检验科
前言
原发免疫性血小板减少症(primary immune thrombocytopenia, ITP)是一种获得性自身免疫性出血性疾病,以无明确诱因的孤立性外周血血小板计数减少为主要特点。该病临床表现变化较大,无症状血小板减少、皮肤黏膜出血、严重内脏出血、致命性颅内出血均可发生。ITP主要发病机制是血小板自身抗原免疫耐受性丢失,导致体液和细胞免疫异常活化,共同介导血小板破坏加速及巨核细胞产生血小板不足。
案例
姚某,27岁,女

血小板危急值,打电话询问病情,患者一周前无明显诱因鼻衄伴牙龈出血,身上无出血点与紫癍。经治疗后好转但牙龈仍有出血,遂来我院门诊检查。查看(Sysmex XN-350)散点图。

血小板直方图翘尾,立即用我实验室Sysmex XN-2000复查。

RET通道PLT-O采用半导体激光和流式细胞技术,利用聚甲烯次甲基荧光染料对血小板进行DNA/RNA染色,在FSC-SFL的散点图上,对血小板进行计数,可有效地排除了电阻抗法(PLT-I)无法排除的部分颗粒的影响。当有小红细胞、细胞碎片、血小板聚集,大血小板时电阻抗方法就会受到干扰。

PLT-F是XN系列血液分析仪新增的用于血小板计数的独立通道。应用了噁嗪染料,对PLT的染色效果更明显,检测颗粒数是PLT-O的5倍,使得PLT在FSC-SFL散点图上更容易与其他细胞分开,其抗干扰的能力更强,在PLT-F通道可以排除小红细胞和红细胞碎片的干扰,并对血小板数字值进行修正。
分别运用了3种方法进行复查,结果大致相同,但发现患者未成熟血小板指数IPF比较高(41.1%),立即推片复查。
显微镜下发现血小板少见、体积偏大。部分红细胞中心淡染区稍扩大。综合分析了患者病情,ITP立刻浮现在我脑海中,立刻与临床沟通,报告危急值并建议进行骨穿和进一步检查。第二天骨穿结果如下:

临床排除了其他导致血小板减少的因素,根据患者症状和检查结果做出了诊断-原发性免疫性血小板减少症,应用了糖皮质激素和免疫球蛋白。四天后复查血常规结果如下:

小结
至此一例血小板减少的面纱揭开了,未成熟血小板指数(IPF)立下了汗马功劳。未成熟血小板又叫网织血小板(RP),是介于骨髓成熟巨核细胞和成熟血小板之间的不成熟血小板,是反映骨髓血小板生成状态的有用指标,未成熟血小板指数(IPF)及绝对值计数(RPC)对于分析骨髓巨核细胞血小板生成动力学和血小板减少机制具有重要意义。
目前ITP的诊断仍基于临床排除法,须除外其他原因所致血小板减少。除详细询问病史及细致体检外,其余诊断要点包括:
1.至少连续2次血常规检查示血小板计数减少,外周血涂片镜检血细胞形态无明显异常;
2.脾脏一般不增大;
3.骨髓检查:ITP患者骨髓细胞形态学特点为巨核细胞增多或正常,伴成熟障碍;
4.须排除其他继发性血小板减少症:自身免疫性疾病、甲状腺疾病、淋巴系统增殖性疾病、骨髓增生异常综合征(MDS)、再生障碍性贫血(AA)、各种恶性血液病、肿瘤浸润、慢性肝病、脾功能亢进、普通变异型免疫缺陷病(CVID)、感染、疫苗接种等所致继发性血小板减少;血小板消耗性减少;药物所致血小板减少;同种免疫性血小板减少;妊娠期血小板减少;先天性血小板减少及假性血小板减少[1]。
通过以上病例的分析,我们可以初步肯定IPF在血小板减少疾病中的应用价值。我相信,随着医学日益的发展,IPF这个重要的检测项目能够为临床实践提供更多的诊断依据!
参考文献:
[1].成人原发免疫性血小板减少症诊断与治疗中国指南(2020年版)[J].中华血液学杂志,2020,41(08):617-623.
来源:学术二区资料分享